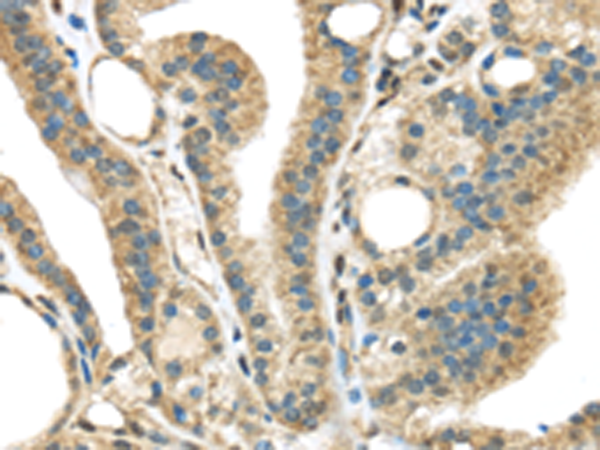

|
Background: |
The protein encoded by this gene is a kinase that is predominantly found in the nucleus. However, it can interact with PDLIM1/CLP-36 in the cytoplasm and localize to actin stress fibers. The encoded protein may be a regulator of actin stress fibers in nonmuscle cells. |
|
Applications: |
ELISA, IHC |
|
Name of antibody: |
STK35 |
|
Immunogen: |
Synthetic peptide of humanSTK35 |
|
Full name: |
serine/threonine kinase 35 |
|
Synonyms: |
CLIK1; STK35L1 |
|
SwissProt: |
Q8TDR2 |
|
ELISA Recommended dilution: |
2000-10000 |
|
IHC positive control: |
Human thyroid cancer |
|
IHC Recommend dilution: |
30-150 |
購物車
購物車 幫助
幫助
 021-54845833/15800441009
021-54845833/15800441009
